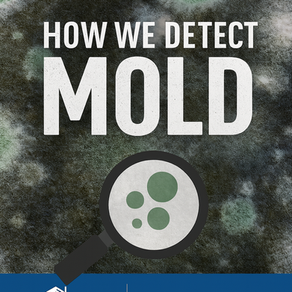
🧪 Part 3: How We Detect Mold Understanding the Tools, Techniques, and Triggers Behind Mold Detection

Tips for Homebuyers
Inside our free, downloadable booklet, we provide you with valuable tips that can help streamline your real estate transaction by making it go quicker and smoother with the help of your InterNACHI® Certified Professional Inspector.
Click the download button to get the Tips for Homebuyers Book now.
What We Inspect and Why
A home inspection is a visual examination of the home's major structure, systems, and components that are visible and safely accessible. Buying a home is typically the biggest investment you will ever make, so it's important to get a home inspection because the inspector can find and document defects that may or may not be obvious to you as a prospective buyer. Such defects can range from simple replacements or repairs to severe damage or safety and health concerns.
-
Interior, exterior, walls, windows, and doors
-
HVAC (heating, ventilation, and air conditioning)
-
Basement, crawlspace, and structure
-
Fireplace
-
Roof and attic
-
Electrical
-
Plumbing

Meet Your Inspector
ERIC FRANK

Eric is a veteran and an InterNACHI-certified home inspector in Jesup & Hinesville, GA. Hundreds of hours of training prepared him to examine all kinds of homes, in addition to performing well, deck and pool inspections.
Eric goes the extra mile for clients by...
-
Offering 10% discounts to veterans and first responders
-
Providing home inspection services on Sunday

We Educate Our Clients
During the home inspection, we will show you how everything in your house works, how to maintain it, and how to save home energy. I will include a 100-page home maintenance book along with your home inspection report. Scientific evidence demonstrates a solid relationship between housing conditions and human health. I will make sure your home supports your health.

how it works

how to maintain it

how to save energy
Watch this 2-min video.
My Promise
Choosing the right home inspector can be difficult. Unlike most professionals you hire, you probably won't meet me until our appointment. Furthermore, different inspectors have varying qualifications, equipment, experience, reporting methods, and pricing.
Ultimately, a thorough home inspection depends heavily on the individual inspector’s own effort. If you honor me by permitting me to inspect your new home, I guarantee that I will give you my very best effort.
This, I promise you.

Our Mission
At Altamaha Home Inspections, our mission is to deliver reliable, comprehensive inspection services that empower homeowners and buyers. Through our commitment to integrity, excellence, and innovation, we aim to provide peace of mind by ensuring homes are safe, sound, and ready for the future.
Core Values
Integrity
Always provide honest, transparent, and thorough inspections to build trust with clients.
Excellence
Commit to the highest standards of professionalism and meticulous attention to detail.
Innovation
Embrace cutting-edge technology, like drone inspections, for more comprehensive and efficient service.
Customer Focus
Prioritize the needs and concerns of clients, ensuring clear communication and expert guidance.
Education
Continually expand knowledge of industry standards to provide clients with informed, valuable insights.

Meet Our Crawlspace Robot